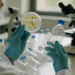
La BUAP estudia bacteria capaz de descomponer PET

En la época actual, marcada por la interconexión y el auge digital, la industria del turismo ha sufrido transformaciones significativas. Aunque internet ha brindado a los viajeros una mayor autonomía para planificar sus propias travesías, las agencias de viajes han sabido adaptarse a este nuevo entorno, encontrando formas de redefinir su propuesta de valor en un mercado en constante evolución.
### La Eficacia de la Personalización
A pesar de la comodidad que ofrecen los clics para reservar un viaje, la experiencia que pueden brindar las agencias de viajes supera las transacciones digitales. Los profesionales de este sector no solo comprenden minuciosamente los destinos, sino que también están capacitados para ofrecer un servicio que responde a las necesidades y deseos específicos de cada viajero. En un mar de opciones que a menudo resulta abrumador, contar con asesoría experta se convierte en un recurso valioso que coloca al viajero en el camino correcto.
Las agencias realizan un análisis detallado y personalizan itinerarios que no solo son atractivos, sino también prácticos y enriquecedores. Cada recomendación se basa en un profundo entendimiento de lo que cada destino puede ofrecer, garantizando una experiencia completamente adaptada al viajero.
### Simplificando el Viaje
Planificar una escapada no es una tarea sencilla. Involucra diversas etapas que van desde la búsqueda de vuelos y alojamientos hasta la elección de actividades locales. En este sentido, las agencias de viajes se presentan como aliados imprescindibles que manejan los detalles complicados, permitiendo que los viajeros enfoquen su energía en disfrutar del viaje.
En situaciones imprevistas, como cancelaciones de vuelos o alteraciones en el itinerario, el papel del agente de viajes es crucial. Su capacidad para resolver problemas rápidamente proporciona a los viajeros una paz mental vital, especialmente en momentos de incertidumbre.
### Acceso a Experiencias Auténticas
Además de la logística, estas agencias poseen la capacidad de conectar a los viajeros con experiencias auténticas que a menudo se pasan por alto en las búsquedas en línea. Desde inmersiones en comunidades locales hasta eventos culturales únicos, el acceso a estos tesoros ocultos no tiene precio.
Este enfoque fomenta un turismo consciente y sostenible, beneficiando a los viajeros y a las comunidades locales al mismo tiempo. Las agencias actúan como defensores de un tipo de turismo que prioriza la autenticidad en lugar de la sobreexplotación.
### La Sinergia entre Tecnología y Asesoría Humana
A pesar del crecimiento exponencial de las plataformas de reserva online, las agencias han encontrado maneras efectivas de integrar la tecnología en sus servicios. Herramientas digitales optimizan sus operaciones, ofreciendo a los clientes una experiencia que conjuga lo mejor de ambos mundos: el toque humano y la eficiencia tecnológica.
El uso de redes sociales, blogs y aplicaciones móviles ha facilitado una comunicación más directa y efectiva entre las agencias y sus clientes. Esta combinación enriquecedora propicia una experiencia de viaje más satisfactoria, en la que la interacción personal y el asesoramiento profesional se integran de manera armónica.
### Reflexiones Finales
En un mundo donde la tecnología y la experiencia humana colisionan, las agencias de viajes conservan un lugar relevante en el ecosistema turístico contemporáneo. Su importancia radica no solo en la capacidad de planificar un viaje, sino en ofrecer una visión integral que enriquece cada experiencia de viaje.
Viajar va más allá de simplemente alcanzar un certificado de vuelo o un billete de entrada; se trata de crear memorias, establecer conexiones y vivir experiencias. En este recorrido, las agencias de viajes destacan como guías, ayudando a los pasajeros a navegar por un paisaje turístico que, aunque emocionante, puede ser complejo. Así, al programar su próxima aventura, los viajeros pueden beneficiarse de la experiencia y dedicación que ofrecen estos profesionales, asegurando que cada viaje sea no solo bien diseñado, sino también profundamente vivido.
Gracias por leer Columna Digital, puedes seguirnos en Facebook, Twitter, Instagram o visitar nuestra página oficial. No olvides comentar sobre este articulo directamente en la parte inferior de esta página, tu comentario es muy importante para nuestra área de redacción y nuestros lectores.